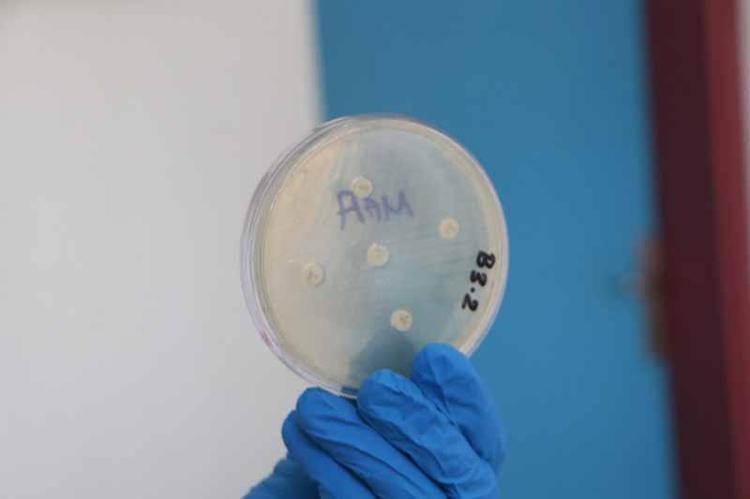

Adana’da gıdaların raf ömrünü uzatacak doğal koruyucular geliştirildi
Adana’da Çukurova Üniversitesi (ÇÜ) Su Ürünleri Fakültesi Öğretim Üyesi Doç. Dr. Yılmaz Uçar, laboratuvar ortamında herhangi bir kimyasal koruyuculara başvurmadan biberiye, kekik, adaçayı gibi bitkisel yağları kullanarak gıdalarda nanoteknolojik doğal koruma sistemi oluşturdu. Çalışmayla, bitkisel kaynaklı doğal bileşenlerle özellikle balık ürünleri, et ve köfte gibi kolay bozulabilir gıdaların sentetik katkı maddeleri kullanılmadan raf ömrünün uzatılabildiği ortaya konuldu.

ÇÜ Su Ürünleri Fakültesi Öğretim Üyesi Doç. Dr. Yılmaz Uçar, TÜBİTAK destekli projesinde biberiye, kekik, adaçayı gibi bitkisel yağları kullanarak nanoteknolojik yöntemlerle gıdalarda doğal koruyucu yöntemler üzerine laboratuvar çalışması başlattı. Bu yöntemle gıdalardaki mikrobiyal bozulmayı önlemeye yönelik deneyler yaptıklarını belirten Doç. Dr. Yılmaz Uçar, “Bu çalışmayla sentetik katkı maddelerine alternatif bir yaklaşım ortaya koyduk” dedi.

BİBERİYE, KEKİK, ADAÇAYI GİBİ DOĞAL YAĞLAR KULLANILDI
Çalışmanın detaylarını paylaşan Doç. Dr. Uçar, “Gıdaların korunmasında doğaya dönük, sürdürülebilir yöntemlere yönelmemiz gerekiyor. Artık günümüzde insanlar da kimyasallardan kaçıyor. Bizim de amacımız daha sağlıklı ürünleri tüketiciye ulaştırmak. Gıda güvenliği alanında yürüttüğümüz araştırmalarda, biberiye, kekik, adaçayı gibi bitkisel yağların nanoemülsiyon formülasyonlarını geliştirdik. Bu yağlar çok eski zamanlarda zaten gıdalarda kullanılıyordu. Geliştirdiğimiz nanoemülsiyonlar, klasik emülsiyonlara göre çok daha küçük damlacık boyutuna sahip. Bu sayede daha geniş temas yüzeyi oluşturarak bakterilere karşı etkinliği artırıyor. Bunları daldırma yöntemiyle gıdaların üzerine uyguladık. İnce bir biyofilm tabakası oluşturduk. Bu bileşenlerin gıda kaynaklı patojen bakterilere karşı antimikrobiyal etki gösterdiğini tespit ettik. Laboratuvar koşullarında yaptığımız testlerde, nano boyutlu formülasyonların bakteriyel gelişimi baskıladığı ve biyojenik amin oluşumunu önemli ölçüde azalttığını ortaya koyduk” diye konuştu.

GIDANIN TADI, KOKUSU VE GÖRÜNÜMÜNÜ DEĞİŞTİRMİYOR
Nanoteknoloji kullanılarak yapılan bu çalışmayla artık gıdaların raf ömrünün daha doğal yöntemlerle uzatılabilmesinin mümkün olduğuna dikkat çeken Uçar, şöyle devam etti:
“Bizim elde ettiğimiz sonuçlar, gıdalarda bozulma ve toksisiteye yol açan kimyasal süreçlerin önlenmesinde yeni ve doğal çözümlere bir kapı araladı. Yavaş yavaş koruyucuların piyasadan kalkması için bu çalışmalarımızı çeşitlendirerek devam ettirmeyi hedefliyoruz. Böylelikle kanserojen olabilecek kimyasalların önüne geçebileceğiz. Amacımız da gıdaları kimyasal koruyuculara başvurmadan daha uzun süre güvenli şekilde saklayabilmek. Nanoteknoloji, bitkisel bileşenlerin etkisini artırarak bunu mümkün kılıyor. Ayrıca nanoformülasyonların gıdanın görünümü, tadı ve kokusu üzerinde olumsuz bir etki yaratmadığı; aksine raf ömrünü uzatarak ürün kalitesini koruduğunu söyleyebiliriz. Bu kapsamda geliştirilen nanoteknolojik çözümler hem tüketici sağlığını koruma hem de gıda israfını azaltma açısından önem taşıyor.”

Uçar, yakın gelecekte tamamen doğal, nanoteknoloji destekli koruma sistemlerinin ticarileşmesini hedeflediklerini sözlerine ekledi.